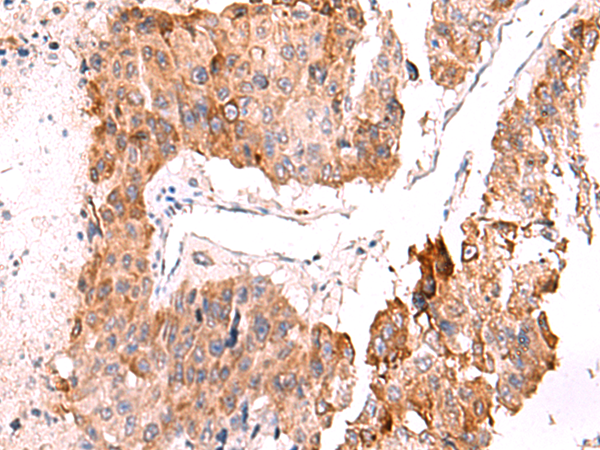

-
分类: 科研抗体货号: P06744别名: LOCR; NPHL2; OCRL1; INPP5F; OCRL-1应用: IHC反应种属: Human, Mouse, Rat
-
分类: 科研抗体货号: P06746别名: IA1; IA-1应用: WB反应种属: Human, Mouse
-
分类: 科研抗体货号: P06738别名: FIL1; FIL1Z; IL-1H; IL-37; IL1F7; IL1H4; IL-1F7; IL-1H4; IL1RP1; IL-1RP1; FIL1(ZETA)应用: WB,IHC反应种属: Human
-
分类: 科研抗体货号: P06788别名: DIF; TNFA; TNFSF2; TNLG1F; TNF-alpha应用: IHC反应种属: Human, Mouse, Rat
-
分类: 科研抗体货号: P06736别名: FIL1; FIL1E; IL1F6; IL-1F6; IL1(EPSILON); FIL1(EPSILON)应用: WB,IHC反应种属: Human, Mouse
-
分类: 科研抗体货号: P06781别名:应用: WB反应种属: Human
-
分类: 科研抗体货号: P06735别名: IFNLR; LICR2; IL28RA; CRF2/12; IL-28R1应用: WB反应种属: Human
-
分类: 科研抗体货号: P06778别名: PLMT; PNMT; PEAMT; PEMPT; PEMT2应用: WB,IHC反应种属: Human, Mouse
-
分类: 科研抗体货号: P06732别名: FD; DYS; IKAP; IKI3; TOT1; IKBKAP应用: WB,IHC反应种属: Human
-
分类: 科研抗体货号: P06777别名: JP1; JP-1; CMT2K应用: WB,IHC反应种属: Human, Mouse

鄂公网安备42018502007531号
鄂公网安备42018502007531号

